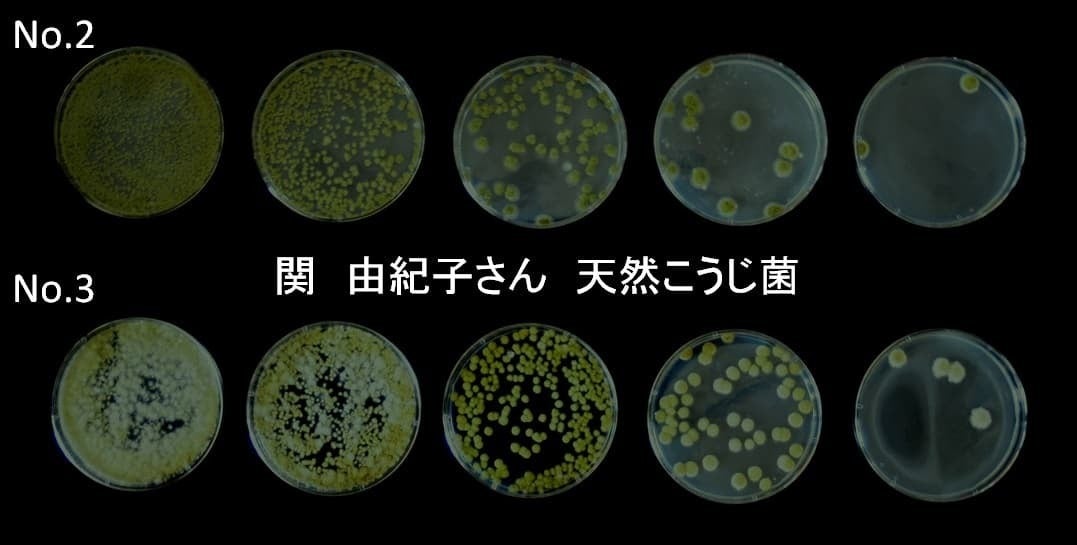

自家採取した種子島の天然麹菌と島の天日塩から酵素の活性が残っている生塩麹を作りたい‼️
たねの島糀店
皆さんこんにちは。
数あるプロジェクトの中からこちらのページを見て頂きありがとうございます。

2017年7月に種子島の空気中から麹菌を採取することに成功しました。
この麹菌と主人の作る太陽と風の力で造る天日塩で酵素の活性が残っている今までにない塩糀を作りたいと思っています。
今回は商品化に向けて、麹を作る為の道具や資材の資金と、より安全性を確保するために採取した麹菌の遺伝子分析費用を皆さんからご協力頂きたいとクラウドファンディングを立ちあげました。
【種子島への移住】

神奈川県で産まれ育ち同郷の主人と結婚しましたがその後すぐに主人が青年海外協力隊に参加。ボリビアで2年間生活し都会での生活に疑問を持ち、少しでも農的生活がしたいと住むところを探す旅に出ました。 ワンボックスカーにテントを積み込み家族4人(長男2才、次男生後6ヶ月)で5ヶ月間の旅の末、移り住んだのがここ種子島でした。 以来地の利を生かした仕事として孟宗竹を使った流下式塩田による天日塩つくりを夫婦でしております。
【発酵のはじまり】


私の発酵のはじまりは地域の人達との味噌作りや島のフルーツを使った天然酵母のパン作りからでした。 実家が造り酒屋だったこともあり、私が天然酵母のパン作りから酒種酵母によるパン作りに移行していったのは自然な流れだったのかもしれ ません。
しかも麹菌があれば日本の調味料を全て作ることが出来ます。 それから少しずつですが麹を作って日本の調味料も作るようになりました。
【空気中から天然麹菌を採取】
そうして麹作りにのめり込んでいった頃お隣の屋久島で麹文化研究家のなかじさんの『稲霊から種麹をつくる』というリトリートに参加。
その時天然麹菌を採取してみたいと言っていた私に、なかじさんが『沖縄には空気中に黒麹菌が浮遊しているというからもしかしたら種子島でも天然の麹菌が採取出来るかもしれませんよ。』と誘って下さり、室町時代から続く種麹屋さんが古来からしていた手法を教えて頂き2017年7月自然界からなんと!麹菌を採取することに成功しました。


【東京工業大学の麹菌のゲノム解析】
2019年12月に公開された東京工業大学とグルナビの共同研究によるゲノム解析により今まで麹の世界では定説とされていたことが覆されました。
https://www.titech.ac.jp/news/2019/045760.html
1つはカビ毒を産生するアスペルギルス-フラバスが長年の人間による家畜化によりフラブスが無毒化され麹菌が生まれたという説。
また麹菌はその産業用途により醤油用、酒用、味噌用のグレードに分類されており、採取元では分類されておらず、今回の分析からこれらのグレードは祖先株の変異の蓄積によるものではなく有性生殖によるものであるということも明らかになりました。
つまり麹菌は太古の昔からカビ毒を産出しない有用菌であり、自然界での有性生殖によりそれぞれの酵素の特異性(醤油用、酒用、味噌用など)もされていたということがわかったのです。
【多数の検査機関からの同定検査拒否】
私が種子島の天然麹菌を採取した2017年にはまだゲノム解析などされておらず、カビ毒を産出する麹菌が存在するという説があった為、同定検査に出そうとしてもカビ毒の危険性を指摘され種麹屋さんで作られる麹菌以外は危険だと殆どの検査機関から検査を拒否されました。 それでもシラミつぶしに連絡して漸く検査してくれるところを見つけカビ毒もなく黄麹菌だと同定されたのが 2018年1月。
それからは自分の採取した麹菌がどんなものなのか調べる為にこの麹菌から色々なものを作りました。 味噌、醤油、酢、味醂、甘酒、塩麹、醤油麹、酒種パンetc.



【秋田今野商店さんとの出会い】
そんな2019年3月。 発酵仲間との発酵旅で種麹屋さんである(株)秋田今野商店さんを訪れた折、開発部長の佐藤勉さんが私の採取した天然麹菌に興味を持って下さり、4種類の麹菌を(なんと私の採取した麹菌は4種類もあったのです。)純正培養して下さり、其々の酵素力価も調べて下さり『自然界から採取した麹菌であり遺伝子検査をすれば安全上の問題もない。』と仰って頂けました。

しかも4種類の麹菌のうちの1つはおそらく麹菌の原種に近いものであり、普通の麹菌の2~3倍の酵素力を持っており、褐変反応もとても強いということでした。 『この麹菌の特徴を生かして面白い塩麹が出来るだろう。』との佐藤さんの言葉に勇気を頂き種子島の天然麹菌から塩麹を開発しようと決意しました。 。

酵素力価が高いということは簡単に言うとこの麹で甘酒を作るととても甘い甘酒が出来て、塩麹を作ると素材の甘みや旨味がより強く出て肉や魚を軟らかくする力も高いということです。 そして麹は酵素力価が高いと褐変反応も高くなる傾向があるのでこの麹菌を米麹にすると白くならずに黒っぽい米麹になります。 麹の業界ではいつの頃からかより白い麹を求められるようになっていったので黒くなる麹は使われなくなってきました。 しかし、国語辞典にも女房言葉で清酒のことを『山吹』と言うと記してあるし、落語の『長屋の花見』でも『お茶の色』を酒にみたてて『おちゃけ(お酒)』というくだりがある。 昔の清酒は黄金色だったようだし、 昔は造り酒屋で酒粕が黒くなってしまった。という話しもよく聞きました。麹は美味しければ白くなくてもいいのでは? そんな想いも込めて今までにない塩麹を商品化します。 2019年11月には秋田今野さんにて種麹作りを教えて頂き、同時に選出した3種類の種子島天然麹菌から実際に米麹を作り其々の特徴を考察しました。 そして更に2種類の麹菌に絞りました。 1つは酵素力価も褐変反応の強いsy1。 もう1つは甘酒や清酒造りに向くsy4。 以来今日までこの2種類の麹菌で色々なものを醸す毎日です。

【麹つくりの道具たちを種子島の地杉で手作りしたい】

これからこの2種類の麹菌で色々なものを醸してゆきたいと考えていますが、先ずは主人の作る天日塩で他にはない塩麹を商品化したいと思っています。 そして商品化するにあたり麹作りの道具達を種子島の地杉を使って手作りしたいと思っています。 今までも拙いながら発酵に必要な麹蓋や卓上醤油搾り機や麹室など自由な発想で手作りしてきました。 麹室については明治 末期の酒造りの権威である野白金一先生が考案した温度による比重差を利用した自然循環換気システムである野白式麹室をオリジナルの発想で再現してみたりしました。
手造りの野白式麹室
今回新たに商品化に向けての麹作りの道具達を手作りするにあたり、種子島で古民家を再生し『植物園がある宿』や『バリアフリーの宿』などをプロデュースした一級建築士の内野康平くんが協力してくれることになりました。 島の色々な素材を生かして新しい建築法を試みた彼の作品はとても素敵で、どんな道具達が出来るのか私自信もとても楽しみです。

『いいものを 少しずつ 手作りで』
をコンセプトに等身大の麹作りをしてゆきたいと思っております。
麹にまつわるモノや種子島の魅力的な返礼品をご用意しております。
是非皆様のご支援をお待ちしております。
【協力してくださった方々からのメッセージ】

㈱秋田今野商店 執行役員 生産.技術部長 バイオインキュベーションセンター長
佐藤勉様
http://www.akita-konno.co.jp/index.html
天然の麹菌が少ないながらも各地で見出されている例がありますが、現在は流通が発達し、人及び物資の往来が頻繁に行われる中で、ある意味種子島という島特有の立地条件が他の地域の菌と違う可能性が大きい麹菌が見つけられたのは今後の商品開発において差別化が出来る可能性があり、また食品における一番大切な安全性の面においても、遺伝子検査により確実に安全な菌である事の検証を行う事に大きな意味があると思います。
種子島ならではの新たな付加価値のある食品が出来る事を期待いたします。

なかじ/麹の学校・麹文化研究者
種子島で自然採取された麹菌が 今回のプロジェクトで遺伝子解析されることは、このプロジェクト単体の成功だけでなく 日本の発酵文化と歴史においても 大きな一歩になると思っています。
日本の発酵文化の根底を支える麹菌ですが その由来や現在、醸造業で使われているような機能性と安全性を併せ持つ「ニホンコウジカビ」が
・日本の自然に存在するのか? ・または人間と関わる以前から存在していたのか?
・また存在するとしても真の意味での「野生の麹菌はいるのか?」
というのは長い間の議論のテーマです。
麹菌は日本文化に大きな影響を及ぼし かつ必要不可欠な存在でありながらも まだまだ分からないことが多くあります。今回のプロジェクトは その麹菌の成り立ちや存在の解像度を上げ また今後の発酵文化への理解を進める上でも 非常に大きな一歩になり得ると信じています。

一級建築士事務所 株式会社studioKANRO 代表 内野康平
関さんとお話しするまで、種子島に麹菌があるなんて知りませんでした。
調味料からパンなども自然のチカラで作り出せる技術をもっと種子島で活躍してほしい、そんな想いから建築の分野でもお手伝いさせていただきます。
地の木材で、麹菌を作り出し、食へとつながると思うとワクワクしてきます。
是非皆様もご支援よろしくお願い致します。
※本プロジェクトはAll-in方式で実施します。目標金額に満たない場合も、計画を実行し、リターンをお届けします。
[プロジェクトへの応援メッセージ]
★Marika Groen (茉莉花)Malica ferments / 移動する発酵
https://www.instagram.com/malica_ferments/
由紀子さんから『天然麹菌』を採取しました!との連絡を受けたのが2017年。
その後紆余曲折の末、『黄麹菌だと同定』されました!と報告を受けたのが2018年。
そして一緒に訪れた秋田今野さんで、その鑑定書を佐藤さんにお見せしたのが2019年。
同年秋、種子島から再び秋田に由紀子さんは飛び、佐藤さんがその採取した菌を純化してくださいました。
2020年種子島の塩屋を訪れた際、その菌で育てた麹でできた塩糀や甘酒を食べさせて頂き、その夢を聞きながら胸が躍ったのは、ついこの間のことのようです。
気づけば、由紀子さんの熱意をそっと陰で見守りながら、そのわくわくドキドキをいつも分けてもらってきました。
種の起源と遷移を問うということは、この黴だけに関わることではなく、わたしたちがどこから来てどこへいくのか、という生命のテーマでもあります。
わたしたちのまわりには無数の目に見えないいのちが漂っていて、そのどれもが少なからず旅をし、その度に変化を遂げてきました。ともすれば、そのひとつひとつに名前をつけたのが人間であって、何を以てして自然とするのかというのは終わりなき題材のひとつです。この度は、それに人生をかけて関わろうとされた由紀子さんご夫妻の再スタートに、心からの祝辞とエールの気持ちをこめて、応援の言葉とさせて頂きます。
★内田華子
内田発酵研究室代表
麹ガラス作家
https://www.facebook.com/hanako.uchida.31
天然の麹菌を採取する感動を分かち合う者としてこのプロジェクトを心より応援します。由紀子さんの情熱によりあまたの縁がここに結実し、酵素力価に優れた種子島の天然麹とご夫妻で築きあげた天日塩による塩糀は「奇跡の生塩糀」と呼べるのではないでしょうか。このロマン溢れる種子島の生塩糀が末永く世に出せますよう、皆様応援を宜しくお願いします。
★TOKONAME STORE
有限会社 山源陶苑
代表取締役 鯉江 優次
http://tokonamestore.com/
関さんと出会った時に、種子島の空気中から麹菌を採取したんですとお聞きしました。
当時からすごく情熱をもって活動されておりました。『天然麹菌を使った、種子島特有の発酵食品を作りだしてほしい』そんな思いから、このプロジェクトを微力ながら応援させていただきます。
★大竹宗久 国際薬膳師
旅する発酵料理人
Facebook 体が喜ぶ食材と薬膳生活主催
今回のプロジェクトを聞いて、まず流石、やっぱり大きく動き出しましたね。というのが僕の第一印象でした。色々お話を聞いていくうちにご夫婦の苦労を楽しみに変えてしまう不思議な力に引き寄せられたのは僕だけではないと思います。僕は薬膳料理を伝えてきて五行、五味、五色を中心に料理を考えていますが、それぞれの味を最大限に引き出してくれるもの、それが塩、塩麹だと思っています。体は口にしたものでできています。是非このプロジェクトが成功することを心から応援しております。
★名前:伊藤公子
味噌ソムリエ、上級麹士、「麹の学校」認定講師
HP:https://itoskoji.com
発酵仲間である関由紀子さんから今着手されているプロジェクトのお話を聞いて「なんてステキなロマンのあるプロジェクトなんだろう!」と思いました。
ご夫婦で全国をまわられて見つけた種子島という地。
そこの自然に寄り添って天日塩を作り、野生の麹菌から起こした麹と合わせて塩麴を作る・・・。その土地にある海水と自然採取した麹菌を、自然を破壊することなくありがたく使わせていただく。まさに新型コロナによって生き方を見直す人が多い中、こんなふうに形にしようとしてる人がいることにとても感銘を受けました。今は忘れ去られようとしている日本の伝統文化をもう一度取り戻そうとするこのプロジェクト。私も似たような思いがあるにもかかわらず形にできないので、せめて応援することで1歩前に進めたらなって思います。みなさんも一緒に応援しませんか?」
★論田裕子
スイス在住 麹の学校認定講師
味噌ソムリエ
https://kojiron.com
2020年の2月に関さんと愛知県西尾市のみやもと糀店さんで一週間毎日一緒に麹を仕込み過ごして、関さんのお仕事ぶり(とにかく関さんがいた場所はどこも綺麗になってる!)と、関さんが麹で起こした天然酵母パンは「天までスキップー!」な美味しさ。こだわり抜いた旦那様のお塩と、天然麹菌(偉業です!)でつくられる生塩麹の魅力は単なる塩麹とは言えない商品になると信じてます。 旦那様の作るお塩は希少でたくさんは作られない現状とお察ししますが、塩麹としての形で多くの方々に届けられることを祈ってます。スイスで日々麹を仕込み、麹愛を伝える一人としても非常に嬉しく、心より応援してます。
最新の活動報告
もっと見る
今年の種麹作り始まりました。
2022/08/06 15:11今年の種麹作りはじまりました。気温28℃~30℃湿度85~88%ほどの高温多湿な種子島の気候を利用して、自然環境のもと麹蓋を使用し一粒一粒大切に育てています。種切りしてから本日で6日め。かなり胞子が成長して綺麗な麹塵色になってきています。大陸からお米の伝来と共に日本にやって来たという麹菌。 種子島は日本の中でも米伝来の土地のひとつとして知られています。古くは日本書紀の「天武紀」にも種子島人のことが何度も登場していて天皇自らが宴会を主宰して種子島人をもてなしたという記述もあります。二毛作で年に2度もお米が収穫できる為に最果ての島がこんなにも珍重されていたことが理解できます。(司馬遼太郎の「街道をゆく」より)しかし、こうして自然環境のもとスクスク育っていく種麹を目にしていると「もしかして麹菌の伝来も種子島からなのでは?」などという気持ちもしてきます。黒潮の流れによってパンや鉄砲も日本に最初に上陸したのは種子島でした。そんなことを思いながら種麹を醸しています。種子島関塩屋枝条架流下式塩田たねの島糀店天然麹菌天然麹菌種麹販売生塩糀乾燥米糀 もっと見る
種麹の販売始めます。
2022/07/21 08:20「たねの島糀店」の種麹予約販売開始 「たねの島糀店」の麹菌は種子島の空気中から採取した天然麹菌です。「たねの島糀店」では室町時代に種麹屋さんがしていた手法を再現し、麹菌を空気中から採取しました。その採取時4種類の麹菌が発見されましたがその中でも優良な麹菌2種(SY1とSY4)を商品化致しました。小さな工房で麹蓋を使用し一粒一粒大切に醸した種麹です。生産量が少ないため、SY1.SY4それぞれお一人様5g(5kg分)税込¥500までの数量限定、予約販売のみとさせて頂きます。SY1は麹菌の中でも原種に近いもので、酵素の力は一般の麹菌の2~3倍。(旨味や甘味を引き出す力が2~3倍ということです。)麹菌は酵素の力が強いと褐変反応も強くなるという性質がある為、この麹菌から作った甘酒や塩糀は白くならずに茶色い色が出やすくなります。茶色い甘酒や塩糀が出来てもこれが「たねの島糀店」の天然麴菌の特徴なのでご安心ください。味噌や醤油、塩糀などにすると旨味や甘味が引き立ちます。甘酒は甘味が強く蜂蜜のような濃厚な仕上がりになります。SY4は褐変反応が弱く造り酒屋さんが好むような白く仕上がりクリアな味です。甘酒やどぶろくなどに適しています。 御注意 1開封は清潔に行って冷暗所に貯蔵して下さい。2防湿に充分ご留意下さい。3長期間経過しますと変質の恐れがありますから、なるべく早くご使用下さい。4海外からのご注文は、お客様から指定の送品方法にて対応させて頂きます。Sy1又はsy4乾燥糀200g¥400生塩糀200g¥600ご注文はFB「たねの島糀店」のメッセンジャーからお願いいたします。ご注文の際にはお名前、ご住所、電話番号をお知らせ下さい。送料は¥84。お支払いは振込み用紙を同封しますので後日お振り込み下さい。ゆうちょダイレクトからですと月に5回まで手数料無料の対象になっております。 もっと見る
たねの島糀店開業致しました。
2022/05/12 15:01クラウドファンディングのリターンも無事送品終了し、地元の道の駅的な店舗に納品して参りました。皆さんのお陰で「たねの島糀店」開業致しました。本当にありがとうございました。これからもよろしくお願いいたします。生塩糀200g¥600乾燥米糀200g¥400 もっと見る




しげ子さんメッセージありがとうございます。 みなさんからの温かい気持ちを頂きたねの島糀店が開業出来ました。これからもお客様とのコミュニケーションを大切にした糀店を目指してゆきたいです。
リターンの麹とお塩、甘酒届きました。 思いがけなくサプライズのように届いて大変嬉しく 少しずつ大切に使っています。 長い努力の成果を共有させて頂きありがとうございます。 弛まぬ努力と精進に感動します。 これからもますますのご発展お祈りして応援しています。 お身体気をつけてご自愛しながら頑張って下さいね。 ありがとうございます。